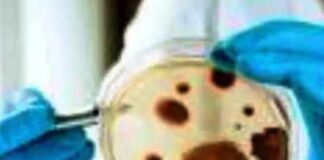
Black fungus cases rise in Andhra Pradesh

Tag: West Godavari
Cyclone Michaung weakens after landfall near Bapatla in Andhra Pradesh
Vijayawada, December 06, 2023 : Heavy rains lashed Tirupati, Nellore, Prakasam, NTR, Krishna, West Godavari and Konaseema districts as the severe cyclonic storm Michaung...
Krishna district beaches lack basic amenities
Tourists from Vijayawada going to Suryalanka beach in Bapatla district
Vijayawada, October 6,2022: Due to no basic amenities at beaches like Manginapudi near Machilipatnam and...
Black fungus cases rise in Andhra Pradesh
Amaravati, September 03, 2021: Andhra Pradesh reported 200 cases of mucormycosis, commonly known as the 'black fungus', in the last eight days, taking the total to...